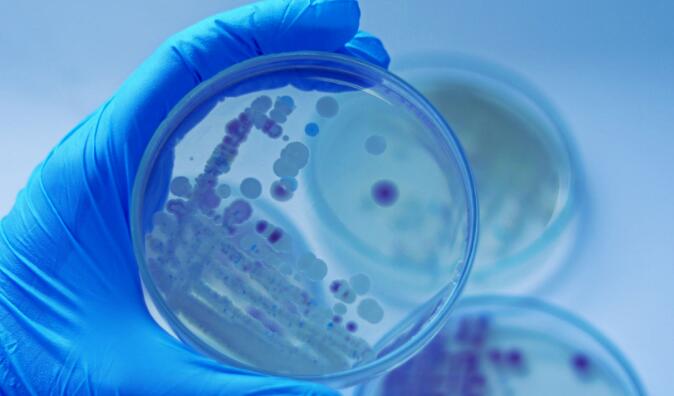
1710396562266576.jpg QQ截圖20240314140820.jpg

空氣微生物采樣系統(tǒng)如何與實時監(jiān)測系統(tǒng)集成

隨著歐盟GMP附錄1的發(fā)布以及對A級和B級環(huán)境中微生物連續(xù)監(jiān)測的要求,空氣微生物采樣成為人們關(guān)注的焦點。在2022年發(fā)布更新的附錄1(無菌藥品生產(chǎn)的歐洲標準)之前,連續(xù)空氣采樣在無菌生產(chǎn)環(huán)境中幾乎是常態(tài)。
為什么空氣采樣器對無菌過程至關(guān)重要?
便攜式和遠程空氣采樣器有什么區(qū)別? 便攜式空氣采樣器 遠程空氣采樣器 主要差異總結(jié)
■ 移動性和靈活性:便攜式空氣采樣器為抽查和有針對性的采樣提供了移動性和靈活性,而遠程空氣采樣器是固定的,設(shè)計用于連續(xù)、自動監(jiān)控。
■ 操作:便攜式采樣器是手動操作的,需要操作員在場,而遠程采樣器是自動操作的,可以集成到更大的監(jiān)測系統(tǒng)中。
■ 應(yīng)用:便攜式采樣器非常適合在不同地點進行多功能現(xiàn)場監(jiān)測。相比之下,遠程采樣器適用于關(guān)鍵領(lǐng)域的連續(xù)監(jiān)測,為趨勢分析和合規(guī)性提供持續(xù)數(shù)據(jù)。
在監(jiān)測系統(tǒng)中實現(xiàn)遠程空氣采樣器。
1.需求評估和規(guī)劃
■ 確定目標:確定持續(xù)監(jiān)控系統(tǒng)的目標,如遵守監(jiān)管標準、確保產(chǎn)品質(zhì)量,或兩者兼而有之。
■ 評估環(huán)境要求:了解行業(yè)和應(yīng)用的具體環(huán)境條件和監(jiān)管要求,重點關(guān)注顆粒物計數(shù)、微生物污染、溫度和濕度等參數(shù)。
■ 定義監(jiān)測點:根據(jù)風(fēng)險評估,確定持續(xù)監(jiān)測至關(guān)重要的關(guān)鍵領(lǐng)域。考慮污染風(fēng)險高的區(qū)域或暴露無菌產(chǎn)品的區(qū)域。
2.遠程空氣采樣器的選擇
■ 選擇合適的技術(shù):選擇滿足您特定需求的遠程空氣采樣器,考慮采樣效率、流速、與相關(guān)微生物類型的兼容性以及與現(xiàn)有系統(tǒng)集成的方便性等因素
■ 評估數(shù)據(jù)管理能力:確保采樣器能夠以與您的連續(xù)監(jiān)測系統(tǒng)兼容的格式提供數(shù)據(jù)。尋找實時數(shù)據(jù)傳輸、自動警報和數(shù)據(jù)記錄等功能。系統(tǒng)設(shè)計與集成
■ 設(shè)計監(jiān)測系統(tǒng):計劃遠程空氣采樣器如何與連續(xù)監(jiān)測系統(tǒng)的其他組件集成,包括溫度、濕度和其他相關(guān)參數(shù)的傳感器。
■ 確保網(wǎng)絡(luò)連接:遠程空氣采樣器需要網(wǎng)絡(luò)連接才能傳輸數(shù)據(jù)。確保您的設(shè)施的網(wǎng)絡(luò)基礎(chǔ)設(shè)施能夠支持從采樣器到中央監(jiān)控系統(tǒng)的安全可靠的數(shù)據(jù)傳輸。
■ 軟件集成:將遠程空氣采樣器與中央監(jiān)控軟件集成,確保采樣器的數(shù)據(jù)能夠有效地收集、分析和存儲。
3.數(shù)據(jù)分析和報告
■ 實施數(shù)據(jù)分析工具:利用軟件工具可以實時分析遠程空氣采樣器收集的數(shù)據(jù)。這些工具應(yīng)該有助于識別趨勢,檢測異常情況,并根據(jù)預(yù)定義的閾值觸發(fā)警報。
■ 制定報告機制:創(chuàng)建報告,總結(jié)系統(tǒng)監(jiān)測的環(huán)境條件。這些報告的設(shè)計應(yīng)支持決策、法規(guī)遵從性和持續(xù)改進過程。
4.合規(guī)性和監(jiān)管注意事項
■ 確保法規(guī)遵從性:確保遠程空氣采樣器和連續(xù)監(jiān)測系統(tǒng)的實施符合相關(guān)法規(guī)和指南,如與潔凈室環(huán)境相關(guān)的美國食品藥品監(jiān)督管理局、歐洲藥品管理局或ISO標準。需要審查的關(guān)鍵文件為ISO 14698和EN17141
■ 文件:保存系統(tǒng)實施的完整文件,包括驗證記錄、校準證書、維護日志和培訓(xùn)記錄。此文檔對于監(jiān)管檢查和審計至關(guān)重要。
5.與質(zhì)量管理體系的集成
■ 鏈接到質(zhì)量系統(tǒng):將持續(xù)監(jiān)控系統(tǒng)與組織的質(zhì)量管理系統(tǒng)(QMS)集成。這確保了數(shù)據(jù)
監(jiān)測系統(tǒng)的見解可以直接為質(zhì)量控制、風(fēng)險管理以及糾正和預(yù)防措施(CAPA)提供信息。
■ 反饋回路:建立反饋回路,以持續(xù)改進監(jiān)控系統(tǒng)及其監(jiān)督的制造過程。使用收集的數(shù)據(jù)來改進流程,提高產(chǎn)品質(zhì)量,降低污染風(fēng)險。
6.可擴展性和未來性
■ 可擴展性計劃:在設(shè)計系統(tǒng)時考慮到可擴展性,允許隨著需求的增長或變化添加更多采樣器或擴展監(jiān)控功能。
■ 隨時掌握最新技術(shù):隨時了解監(jiān)控技術(shù)和軟件分析的進展。使用新技術(shù)升級或擴展您的系統(tǒng)可以提高其有效性和效率。
7.持續(xù)學(xué)習(xí)和改進
■ 鼓勵持續(xù)學(xué)習(xí):培養(yǎng)重視持續(xù)學(xué)習(xí)和改進的組織文化。利用從中獲得的見解為員工提供培訓(xùn)和發(fā)展機會的監(jiān)控系統(tǒng)
■ 參與行業(yè)發(fā)展:參加行業(yè)論壇、研討會和會議,了解與環(huán)境監(jiān)測相關(guān)的最佳實踐和監(jiān)管發(fā)展。